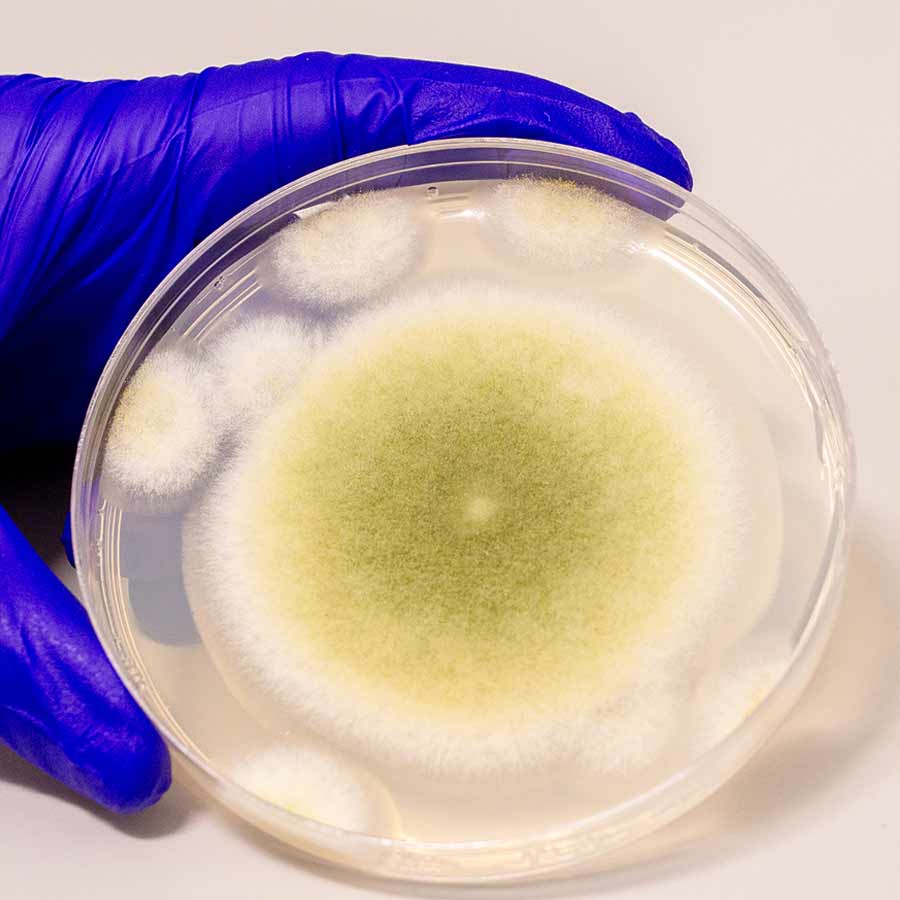
‘অ্যাসপারগিলাস ফ্ল্যাভাস’ ছত্রাক।

মিশরের ফ্যারাও তুতেনখামেনের সমাধির সঙ্গে নাকি ‘অভিশাপ’ জড়িয়ে। যাঁরা সেই সমাধি খুলেছিলেন, সেই পুরাতাত্ত্বিকদের অধিকাংশই অকালে প্রাণ হারান। রটে যায়, ‘মমির অভিশাপে’ই নাকি তাঁদের মৃত্যু হয়েছে। দশকের পর দশক ধরে এই ধারণা লোকমুখে প্রচলিত ছিল। পরে জানা যায়, কোনও ‘অভিশাপ’ নয়, এর নেপথ্যে একটি বিষাক্ত ছত্রাক। ওই ছত্রাকের সংক্রমণই অনেকের মৃত্যুর কারণ। এ বার জানা গেল, ওই প্রাণঘাতী ছত্রাকই সারাতে পারে রক্তের ক্যানসারের (লিউকেমিয়া) মতো জটিল ব্যাধিও। সাম্প্রতিক এক গবেষণায় এমনটাই জানতে পেরেছেন বিজ্ঞানীরা।
প্রাচীন মিশরের সঙ্গে বিভিন্ন রহস্যময় কাহিনী জড়িয়ে রয়েছে। তেমনই একটি হল ‘তুতেনখামেনের অভিশাপ’ বা ‘মমির অভিশাপ’। মাত্র ৯ বছর বয়সে মিশরের ফ্যারাও হন তুতেনখামেন। প্রায় ১০ বছর রাজত্ব করার পরে ১৯ বছর বয়সেই মৃত্যু হয় তাঁর। কিন্তু ১৯২২ সালের আগে পর্যন্ত এই কিশোর ফ্যারাওয়ের বিষয়ে বিশেষ কিছুই জানা ছিল না বিশ্ববাসীর। ওই বছরের নভেম্বরে ব্রিটিশ প্রত্নতাত্ত্বিক হাওয়ার্ড কার্টার খুঁজে পান তুতেনখামেনের সমাধি। কথিত আছে, প্রায় তিন হাজার বছর আগের ওই মমির শবাধার খুলতেই ‘অভিশাপ’ ছড়িয়ে পড়ে।
সমাধি খনন এবং মৃত্যুরহস্য
তুতেনখামেনের সমাধির খোঁজে কার্টারের পৃষ্ঠপোষক ছিলেন ব্রিটিশ ধনকুবের লর্ড কার্নারভন। সমাধি খননের জন্য আর্থিক সাহায্যও করেছিলেন তিনি। ঘটনাচক্রে, ওই মমি আবিষ্কারের এক বছরের মধ্যেই তাঁর মৃত্যু হয়। রেজ়র দিয়ে দাড়ি কাটার সময় তাঁর গালে সামান্য কেটে যায়। পরে তা থেকেই সংক্রমণ ছড়িয়ে মৃত্যু হয় কার্নারভনের। ঘটনার এক দিন পরেই তাঁর পোষ্য সারমেয়েরও মৃত্যু হয়। পর পর এই দুই মৃত্যু ঘিরেই জন্ম হয় ‘অভিশাপ’ তত্ত্বের। বিখ্যাত গোয়েন্দা চরিত্র শার্লক হোম্সের স্রষ্টা আর্থার কোনান ডয়েলও এই তত্ত্বে বিশ্বাস করতেন। সাংবাদিকদের প্রশ্নে তিনিও বলেছিলেন, মমির ‘অভিশাপে’ই মৃত্যু হয়েছে কার্নারভনের।
এর পর থেকে তুতেনখামেনের সমাধির খোঁজে জড়িত থাকা ব্যক্তিদের মৃত্যুর সঙ্গে কিছু না কিছু ‘অভিশাপ’ তত্ত্ব জুড়ে যেতে শুরু করে। কার্টারের এক সহযোগী আর্সেনিক বিষক্রিয়ায় মারা যান। এক জন মানসিক ভারসাম্য হারিয়ে আত্মহত্যা করেন। সমাধি পরিদর্শনের পরে আত্মহত্যা করেন এক প্রত্নতত্ত্ববিদ। ওই মমির এক্স-রে যিনি করেছিলেন, তিনিও মারা যান এক অজানা রোগে। যদিও যিনি এই প্রত্নতাত্ত্বিক দলের নেতৃত্বে ছিলেন, সেই কার্টার সুস্থ শরীরেই ৬৪ বছর বয়স পর্যন্ত বেঁচে ছিলেন।
‘মমির অভিশাপ’ নয়, দায়ী বিষাক্ত ছত্রাক
যদিও এই ‘মমির অভিশাপ’ তত্ত্ব অনেক আগেই উড়িয়ে দিয়েছেন বিজ্ঞানীরা। বিজ্ঞানীদের অনুমান, সমাধির ভিতরে থাকা এক বিষাক্ত ছত্রাক থেকেই সংক্রমণ ছড়িয়ে মৃত্যু হয়ে থাকতে পারে। যাঁরা আত্মহত্যা করেছেন, তাঁরাও কোনও না কোনও মানসিক চাপে ভুগছিলেন বলে সন্দেহ বিজ্ঞানীদের। পরবর্তী সময়ে গবেষণায় দেখা যায়, এর নেপথ্যে রয়েছে ‘অ্যাসপারগিলাস ফ্ল্যাভাস’ নামে একটি বিষাক্ত ছত্রাক। হাজার হাজার বছর ধরে বদ্ধ জায়গায় থাকার ফলে এই ছত্রাকের রেণু থেকে ফুসফুসের মারাত্মক সংক্রমণ হতে পারে। সত্তরের দশকেও একই রকম ভাবে মৃত্যুর ঘটনা দেখা গিয়েছে। ওই সময় পোল্যান্ডের এক প্রাচীন রাজার সমাধিতে প্রবেশ করেছিলেন ১২ জন গবেষক। তাঁদের মধ্যে ১০ জনেরই এই ছত্রাকের সংক্রমণে মৃত্যু হয়।

‘অ্যাসপারগিলাস ফ্ল্যাভাস’ ছত্রাক। ছবি: সংগৃহীত।
প্রাণও বাঁচাতে পারে বিষাক্ত ছত্রাক!
প্রাণঘাতী ওই ছত্রাকের এ বার নতুন বিশেষত্ব খুঁজে পেয়েছেন বিজ্ঞানীরা। যে ছত্রাককে এত দিন তুতেনখামেনের সমাধি খুঁজে বার করা প্রত্নতাত্ত্বিকদের মৃত্যুর জন্য দায়ী করা হত, সেই ছত্রাকই বাঁচাতে পারে জীবন। মুক্তি দিতে পারে ক্যানসার থেকে। এই ছত্রাক ব্যবহার করে দু’টি নতুন যৌগ তৈরি করেছেন গবেষকেরা, যা ক্যানসার কোষকে ধ্বংস করে দিতে পারে। সম্প্রতি ‘নেচার কেমিক্যাল বায়োলজি’ জার্নালে এই গবেষণা সংক্রান্ত একটি প্রতিবেদন প্রকাশিত হয়েছে। তাতে দেখা গিয়েছে, এই ছত্রাক এমন কিছু পদার্থ উৎপাদন করে যা মানবদেহের লিউকেমিয়া (রক্তের ক্যানসার) কোষকে নষ্ট করে দিতে পারে। বিষাক্ত ছত্রাকে এই পদার্থটি আগেও তৈরি হত, তবে এর গুনাগুণ এত দিন পর্যন্ত অজানাই ছিল।
গবেষণায় উঠে এসেছে, ছত্রাকটি ‘রাইবোজোমালি সিন্থেসিস্ড অ্যান্ড পোস্ট-ট্রান্সলেশনালি মডিফায়েড পেপটাইড’ সংক্ষেপে ‘রিপ’ নামে একটি জৈব অণু তৈরি করে। এই জৈব অণুগুলি দেখতে অনেকটা রিংয়ের মতো। ‘বিবিসি সায়েন্স ফোকাস’ জার্নালেও এই নতুন খোঁজের কথা প্রকাশিত হয়েছে। গবেষকেরা এখনও পর্যন্ত ছত্রাক থেকে চারটি ‘রিপ’ আলাদা করেছেন এবং সেগুলি দিয়ে পৃথক পৃথক যৌগ গঠন করেছেন। তার পরে ক্যানসার কোষের বিরুদ্ধে কার্যকারিতা পরীক্ষা করার সময়, দু’টি ক্ষেত্রে ইতিবাচক ফল মিলেছে। তৃতীয় যৌগটি মার্কিন ওষুধ নিয়ামক সংস্থা ‘এফডিএ’ অনুমোদিত কেমোথেরাপির ওষুধ সাইটারাবাইন এবং ডাউনোরুবিসিনের মতো কাজ করেছে।
তবে ওই বিষাক্ত ছত্রাকে ‘রিপ’ স্বল্প পরিমাণেই খুঁজে পাওয়া গিয়েছে। বায়ো ইঞ্জিনিয়ারিং গবেষক শেরি গাওয়ের কথায়, “ছত্রাকের যে জৈব অণু তৈরির সম্ভাবনা রয়েছে, তা আমরা জানি। তবে এই সম্ভাব্য অণুগুলির খুব সামান্যই এখনও পর্যন্ত আবিষ্কৃত হয়েছে।” এই জৈব অণু দিয়ে তৈরি যৌগ মানবদেহের কোষে প্রবেশ করলে সেটি কোষ বিভাজন আটকে দেওয়ার ক্ষমতা রাখে বলে মনে করছেন তিনি। তবে এখনও পর্যন্ত এটি শুধুমাত্র লিউকেমিয়া কোষের ক্ষেত্রেই কার্যকর। অন্য ক্যানসার কোষের বিরুদ্ধে সেই সাফল্য দেখা যায়নি। গাওয়ের মতে, ‘রিপ’ কী ভাবে ক্যানসার কোষকে ধ্বংস করে, তা নিয়ে আরও গবেষণার প্রয়োজন রয়েছে।












